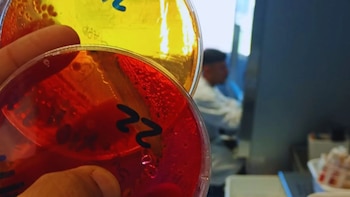
El laboratorio avícola del INTA se suma a la RedLab y refuerza el control sanitario del sector

En plena primavera, cuando los colores y los aromas comienzan a llenar los paisajes, hay una planta que no pasa desapercibida: la lavanda. Más allá de su belleza y su suave perfume, este cultivo tiene un papel clave en la agroecología y el bienestar. Lo que pocos saben es que la primavera es un excelente momento para plantar lavandas, ya que su ciclo de vida perenne se adapta perfectamente al riego constante y a la preparación del suelo.
La lavanda se ha convertido en un cultivo esencial en países como Francia, España y Italia, mientras que en Argentina, una experiencia familiar como Lavandas del Limay en la Patagonia está revolucionando su cultivo bajo un enfoque completamente agroecológico.
La lavanda y su rol en la agroecología
El cultivo de lavanda en Argentina está creciendo con fuerza, y no es casualidad que muchos productores opten por un enfoque agroecológico. ¿Qué significa esto? Se trata de un sistema de producción que evita los agroquímicos tradicionales, priorizando el uso de bioinsumos y prácticas que respetan el equilibrio natural del ecosistema. Lavandas del Limay, ubicada a orillas del río Limay en la estepa patagónica, es un ejemplo claro de este compromiso.

“Todo lo que aplicamos a nuestras plantas es natural”, explica Cristian Signorelli, uno de los propietarios de la finca. Aquí, no solo se evita el uso de químicos, sino que también se adoptan prácticas como el riego por goteo automatizado y el manejo eficiente de los nutrientes del suelo. Estos procesos garantizan un producto final más puro, desde el cultivo de las flores hasta la obtención de los aceites esenciales y las flores secas, que se usan en cosméticos y aromaterapia.
La etapa de cultivo requiere de un manejo cuidadoso para garantizar una buena floración. El riego es un aspecto clave, especialmente en zonas áridas como la Patagonia. Si bien la lavanda es una planta resistente a la sequía, necesita riego durante los primeros meses después de la plantación y en las épocas más secas del año. En el caso de Lavandas del Limay, el uso de riego por goteo permite aprovechar al máximo el agua, evitando el desperdicio y asegurando que las plantas reciban la cantidad exacta que necesitan.
La poda también es esencial para mantener la salud y productividad de las plantas. Después de la floración, la lavanda se poda para estimular el crecimiento de nuevos brotes y mantener su forma. Algunas variedades, como el lavandín o la angustifolia, florecen una vez al año, mientras que otras, como la lavándula dentata, pueden florecer varias veces durante el verano. La poda permite obtener flores frescas y ramas para la producción de aceites esenciales, así como productos decorativos.
¿Por qué la lavanda es tan especial?
Además de su impacto en la producción sustentable, la lavanda tiene propiedades increíbles. Aunque muchos la conocen por su función ornamentativa, esta planta arbustiva perenne, originaria de la región mediterránea, tiene aplicaciones que van desde la cosmética hasta la aromaterapia, pasando por infusiones, aceites esenciales y productos de bienestar personal.
Su aroma relajante ha sido recomendado durante siglos para calmar los nervios y reducir la ansiedad. Estudios científicos respaldan estos beneficios: se ha demostrado que el aceite esencial de lavanda puede tener un efecto positivo en el sistema nervioso, ayudando a disminuir el estrés y mejorar el sueño. No es raro que sea uno de los ingredientes favoritos en sales de baño, jabones y aceites para masajes.
Su versatilidad va más allá del bienestar personal. La lavanda es una de las estrellas en la producción de aceites esenciales, que no solo se usan en cosmética natural, sino también en productos alimentarios y farmacéuticos. Además, las flores secas se utilizan como decoración en arreglos florales y como ingredientes en infusiones y bebidas artesanales.
El auge internacional del cultivo
Aunque los famosos campos de lavanda de Provenza, Francia, son los más conocidos en el mundo, el cultivo de esta planta se ha expandido a regiones tan variadas como España, Italia, Estados Unidos y Australia. Según datos del World Lavender Market Research, se espera que el mercado de productos derivados de la lavanda crezca a un ritmo anual del 4.1% en los próximos años, debido a la creciente demanda de productos naturales y sus aplicaciones en el sector cosmético y de bienestar.
En la Patagonia argentina, Lavandas del Limay no solo ha logrado adaptar el cultivo a un clima árido y desafiante, sino que ha encontrado en la lavanda una forma de potenciar tanto el negocio como el ambiente. El apoyo del INTA Bariloche ha sido fundamental en este proceso, ayudando a implementar tecnologías avanzadas como sensores que miden la humedad del suelo y optimizan el uso del agua en un entorno seco.
Producción sin químicos, para un futuro más saludable
Una de las grandes ventajas de la producción agroecológica es que permite obtener productos totalmente libres de agroquímicos y fertilizantes químicos. Esto no solo es bueno para el ambiente, sino también para los consumidores, que buscan cada vez más productos naturales y saludables. En Lavandas del Limay, cada paso del proceso, desde el cultivo de la lavanda hasta la obtención de los aceites esenciales, está pensado para minimizar el impacto ambiental y garantizar un producto final de alta calidad.
El hecho de que los productos de la finca sean 100% naturales no solo aporta valor en el mercado, sino que también refleja una filosofía de vida sostenible que cada vez más personas están adoptando. Desde jabones y biocosméticos hasta aceites esenciales y flores secas, la lavanda se convierte en un puente entre la belleza natural y el bienestar personal.
Un futuro que huele a lavanda
La lavanda, con su fragancia inconfundible y sus tonos vibrantes, sigue ganando terreno en la agricultura sostenible. Ya sea como planta ornamental, como ingrediente en cosmética o como remedio natural para la ansiedad, esta planta tiene un futuro floreciente en la agroecología. Y con experiencias como las de Lavandas del Limay, queda demostrado que es posible cultivar respetando la naturaleza, mientras se crean productos de calidad que nos cuidan a todos.
Fuente: Inta
Últimas Noticias
El laboratorio avícola del INTA se suma a la RedLab y refuerza el control sanitario del sector
La incorporación del laboratorio garantiza la elaboración de análisis oficiales y mejora las respuestas al sector productivo nacional
La soja, impulsada por la suba de fertilizantes, del petróleo y de los biocombustibles, reconfigura la siembra global
La crisis en Medio Oriente ¿redefine la siembra mundial y el negocio de los granos?

El agro impulsa la actividad económica
En febrero el Índice Compuesto Coincidente de la Actividad Económica -elaborado por las Bolsas de Comercio de Rosario y Santa Fe- registró su tercera suba, pero persisten señales de fragilidad en sectores como las ventas minoristas y el empleo registrado.

El Estado se queda con $62,50 de cada $100 generados por una hectárea agrícola
La suba de costos, impulsada por el aumento de la urea y los combustibles, eleva el peso de los impuestos. ¿Cómo afectan a la próxima campaña de trigo la guerra en Medio Oriente y el estrecho de Ormuz?

Un queso con identidad: Tafí del Valle logra el primer sello de origen lácteo del país
¿Puede un reconocimiento territorial transformar la proyección internacional de un alimento?



